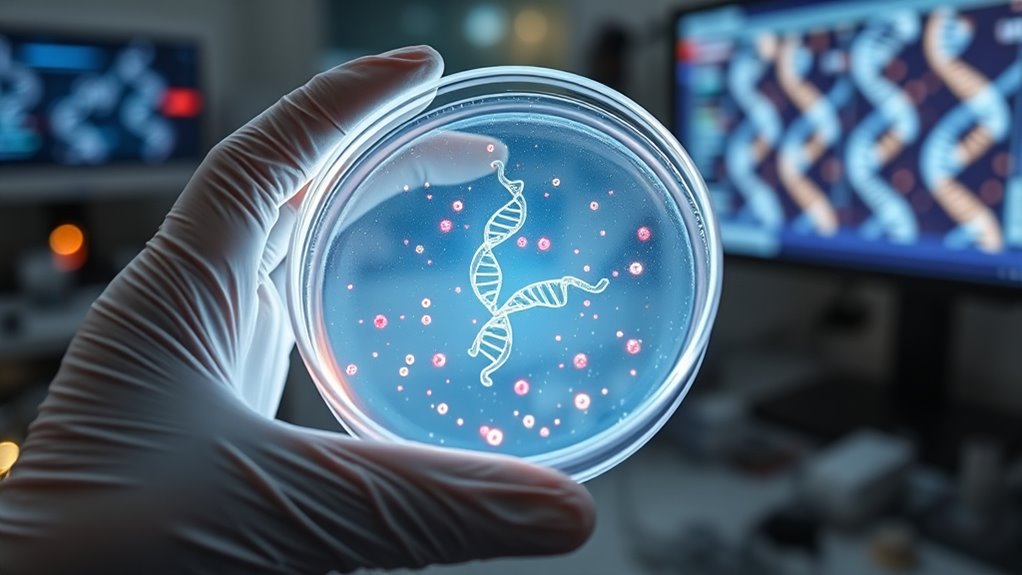
gene editing ethical considerations

Gene therapy for rare diseases offers new hope by targeting the root genetic causes with advanced tools like CRISPR and viral vectors. These approaches can potentially cure or markedly improve conditions that traditional treatments only manage. As the field evolves, ethical questions and safety concerns remain, but ongoing research aims to make therapies more effective and accessible. If you want to explore how these innovations might impact future treatments, there’s more to discover ahead.
Key Takeaways
- Gene therapy targets the root genetic causes of rare diseases, offering potential long-term or curative solutions.
- Advances like CRISPR enable precise editing to correct faulty genes in rare disease patients.
- Ethical considerations, including safety, consent, and off-target effects, influence gene therapy development for rare conditions.
- Challenges such as accessibility, high costs, and potential unintended effects must be managed for wider adoption.
- Ongoing research and regulation are essential to ensure safe, equitable, and responsible use of gene therapy in rare disease treatment.
Gene therapy is transforming the way we approach rare diseases, offering new hope for patients who previously had limited treatment options. With advancements in gene editing technologies like CRISPR, scientists can now precisely target and modify faulty genes responsible for these conditions. This breakthrough not only opens doors for potential cures but also accelerates the development of personalized treatment plans. Additionally, ongoing research into synthetic biology enhances our ability to engineer genetic material more effectively. However, as promising as gene editing is, it raises important ethical considerations that you should understand. Altering human genes touches on moral questions about safety, consent, and the potential for unintended consequences. It’s vital to weigh the benefits of eradicating disease against the risks of off-target effects or irreversible changes to the human genome.
When implementing gene therapy, you’re fundamentally introducing, removing, or repairing genetic material within a patient’s cells. This process can be done using viral vectors, nanoparticles, or direct gene editing methods like CRISPR-Cas9. The goal is to correct a genetic defect at its source, providing a long-term or even permanent solution. For rare genetic diseases, where options are often limited and traditional treatments may only alleviate symptoms, gene editing offers a transformative approach. It allows you to target the root cause, potentially curing the disease rather than just managing its symptoms.
But with this power comes responsibility. Ethical considerations come into play in several ways. For example, germline editing, which affects future generations by altering eggs or sperm, raises questions about consent and the moral implications of making irreversible changes to the human gene pool. You must also consider the accessibility and fairness of these therapies. Will they be available only to the wealthy, or can they be made accessible to all who need them? Additionally, there’s concern about unintended genetic modifications, which could introduce new health issues or genetic abnormalities. Responsible research and strict regulation are necessary to balance innovation with safety.
As you explore gene therapy for rare diseases, it’s essential to stay informed about the ongoing ethical debates and scientific advancements. The field is rapidly evolving, and each breakthrough brings new possibilities—and new questions. While gene editing holds immense promise for transforming lives, it also demands careful ethical considerations to make certain that this powerful technology is used responsibly. Ultimately, your understanding and engagement with both the scientific and moral aspects will shape how gene therapy develops and how it benefits future generations.
CRISPR gene editing kits
As an affiliate, we earn on qualifying purchases.
As an affiliate, we earn on qualifying purchases.
Frequently Asked Questions
What Are the Long-Term Effects of Gene Therapy?
You might wonder about the long-term effects of gene therapy. While it often offers durable treatment, long-term safety remains a concern, as some risks like immune responses or unintended genetic changes could emerge over time. Ongoing studies focus on ensuring treatment durability and monitoring for unforeseen effects. It is crucial to stay informed, as advances continue to improve safety and effectiveness for lasting benefits.
How Much Does Gene Therapy Typically Cost?
You should know that gene therapy typically costs between $375,000 and $2 million per treatment. Cost considerations include the high development expenses and personalized nature of treatments, which influence pricing strategies. While some insurers cover parts of the cost, affordability remains a challenge. Understanding these factors helps you evaluate the financial implications and the value of such innovative therapies for rare diseases.
Are There Any Approved Gene Therapies for Rare Diseases?
You’ll be amazed to learn there are several approved gene therapies for rare diseases, revolutionizing treatment options. These gene therapy applications target specific genetic mutations, offering hope where little existed before. However, ethical considerations remain vital, ensuring safety and equitable access. As breakthroughs continue, you’ll see more of these therapies approved, transforming lives and pushing the boundaries of medical science—truly a new dawn for rare disease treatment.
How Is Patient Eligibility Determined for Gene Therapy?
You determine patient eligibility by reviewing specific eligibility criteria, which include factors like age, disease type, severity, and overall health. Your role involves conducting thorough patient selection, ensuring they meet the set standards for safety and potential benefit. You may perform genetic testing and assess medical history, working closely with specialists to confirm that the patient fits the criteria and is a suitable candidate for gene therapy.
What Are the Risks of Gene Therapy Side Effects?
Think of gene therapy as planting a seed—there’s a chance it might not grow as expected. Side effects can include immune response, where your body recognizes the new gene as a threat, and issues with vector safety, such as inflammation or unintended effects. These risks highlight the importance of careful monitoring and selecting the safest vectors, so you can benefit from the therapy with minimized danger.
viral vector gene therapy products
As an affiliate, we earn on qualifying purchases.
As an affiliate, we earn on qualifying purchases.
Conclusion
You now see how gene therapy offers hope for rare diseases, transforming lives where little else could. As research advances, it’s clear that targeting faulty genes can truly make a difference, turning despair into possibility. While challenges remain, the progress suggests a future where personalized treatments become standard. Believe in the power of science—because with continued innovation, you could be part of a world where no disease is too rare to overcome.
genetic testing kits for rare diseases
As an affiliate, we earn on qualifying purchases.
As an affiliate, we earn on qualifying purchases.
gene therapy treatment kits
As an affiliate, we earn on qualifying purchases.
As an affiliate, we earn on qualifying purchases.